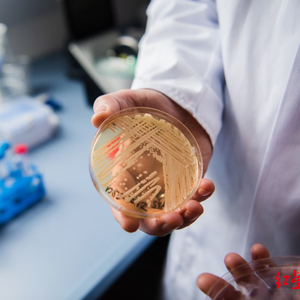

当地时间3月20日,美国疾病控制和预防中心(CDC)表示,耳念珠菌正在以“惊人的速度”传播,目前已遍布美国一半以上的州,成为紧迫的公共卫生威胁。
根据研究,耳念珠菌的主要威胁群体是免疫系统较弱的老年人,并且对于常见的抗真菌药物具备耐药性。从2019年到2020年,美国的感染人数增加了59%,达到756人,2021年感染人数增加了95%,达到1471人,2022年感染人数进一步上升,达到2377人。

德国维尔茨堡实验室中的培养皿中含有耳念珠菌
耳念珠菌最早于2016年在美国出现,当时该真菌主要出现在纽约和伊利诺伊州。但到2021年,这一真菌已经蔓延至全美50个州的一半以上。
据CDC称,近一半感染了耳念珠菌的患者会在90天内死亡,而且在受感染的住院病人中,估计有30%至70%的人最终会死亡。但CDC真菌疾病部门的医务官员梅根·莱曼说,该机构不清楚有多少死亡可以直接归咎于这种真菌。因为被感染的人通常还面临着其他多种健康问题,因此耳念珠菌既可能是直接死亡原因,也可能是与其他不良健康因素一起加速死亡的原因。
纽约流行病专家瓦利德·贾韦德表示,新的发现“令人担忧”,由于感染通常发生在患有健康问题的重病患者身上,因此主要任务是防止真菌传播给医院重症监护病房的患者,但不幸的是,此类真菌具有极端生存和繁殖能力。CDC的专家说,这种真菌传播范围的扩大表明,制定强有力的感染控制计划十分有必要。据悉,耳念珠菌能停留较长时间,并且能通过病人和被污染的物体传播。
“由于真菌会在表面停留很长时间,因此对医院进行彻底清洁具有挑战性。医疗机构常用的一些消毒剂对这种真菌不起作用。”莱曼说。美国范德比尔特大学医学中心传染病部门的医学教授威廉·沙夫纳说:“如果(真菌)进入了医院,就很难控制和消灭。就算感染防控小组和医院里的每个人都做出了最大的努力,但它们可以持续存在,在相当长一段时间内造成感染。”
美国官员说,新冠疫情很可能加剧了耳念珠菌的传播。因为随着公共卫生部门对新冠病毒的关注度提升,导致对耳念珠菌筛查的重视程度降低。此外,耳念珠菌容易附着在护理服、手套和其他个人防护装备上。在理想情况下,这些装备应该经常更换,但由于疫情期间供应短缺,这些装备在经常被重复使用,可能也加速了真菌传播。据悉,该真菌也可以附着在呼吸机或其他医疗设备上。
来源:红星新闻